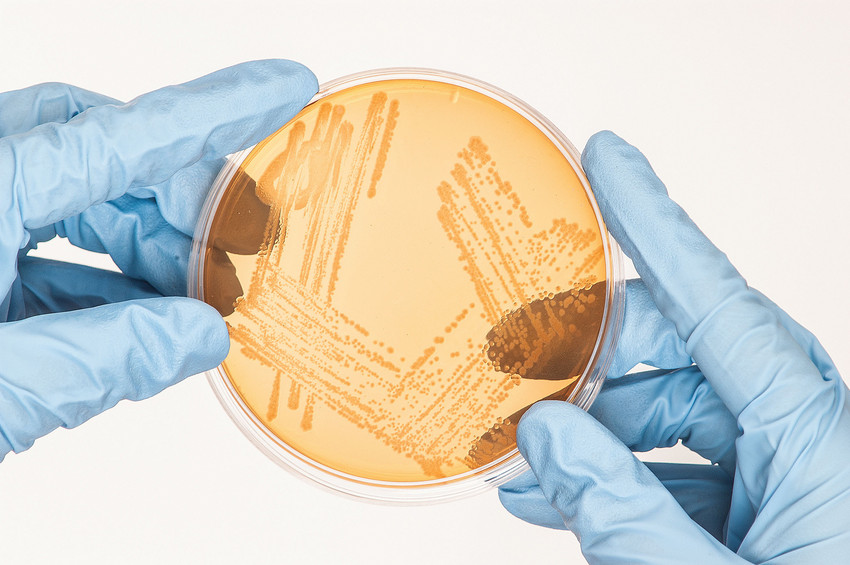
Ulster University spin-out company StimOxyGen raises £1.5 million to advance key preclinical studies, scale-up manufacturing, and expand its team as it moves towards clinical translation.

Read the full article: bit.ly/3XKILq6

#WeAreUU

Research & Innovation
@uuresearchinnov
News and events from Research and Innovation. Developing world-leading research, creating innovative solutions for the benefit of all.
ID: 58775974
http://ulster.ac.uk/research 21-07-2009 11:57:41
8,8K Tweet
4,4K Followers
515 Following


ARK turns 25 🎉 To celebrate its milestone anniversary, we launched ‘ARK at 25’ at a special event held at Belfast City Hall. Learn more about ARK and its exciting plans for 2025: ulster.ac.uk/news/2025/febr… #WeAreUU | Research and Innovation @Queen's


Meet Dr Leanne McCormick. This LGBTQ+ History Month, we reflect on overlooked queer histories. Historian Leanne McCormick uncovers these hidden narratives.. Learn more about her work on the Queer NI project: bit.ly/437hXE6 #WeAreUU


Congratulations Erin McEvoy! Erin was announced as the NI Regional Winner of FameLab for her talk entitled “Deflating the marketing balloon destroying the lives of Irish women”. Why Erin's talk inspired the judges: bit.ly/4kcgum9 #WeAreUU | Ulster University Business School










Meet Professor Michael Brennan. Innovation & sustainability are shaping the future & Michael's research is at the forefront of this transformation. Read how Michael is driving meaningful change in sustainability: bit.ly/3FIoRWC #WeAreUU | Ulster University Business School




As AI becomes part of everyday life, our researchers are examining how the technology may be used in future judicial decisions. Read more: ow.ly/Z0rs50Vt7cc #WeAreUU | UlsterUniSchoolofLaw | John Keers | Department for Science, Innovation and Technology



🚀 Exciting R&D news from CARL at Ulster! We welcomed Boston-based Deoglas as they explore eye reflexes & cognitive load. Also great to collaborate with Education Authority & Ulster Psychology on Neurological Enhancement projects. 📩[email protected] #WeAreUU #DigitalTransformation


A great turnout at Titanic Hotel Belfast today to celebrate My Home Life NI promoting quality of life for people who live in, visit and work in our care homes. #ProudofMHLNI #MHLNI2025🥳